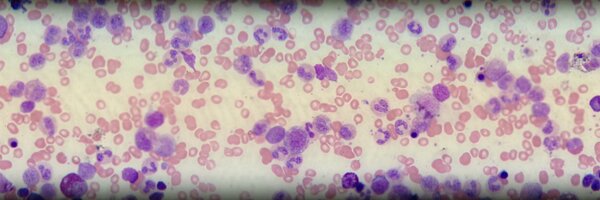
peterknopick Profile Banner

Peter Knopick
@peterknopick
Followers
91
Following
1K
Media
78
Statuses
1K
Assistant Professor, Medical Laboratory Science
Winona, MN
Joined April 2011
No tweets found